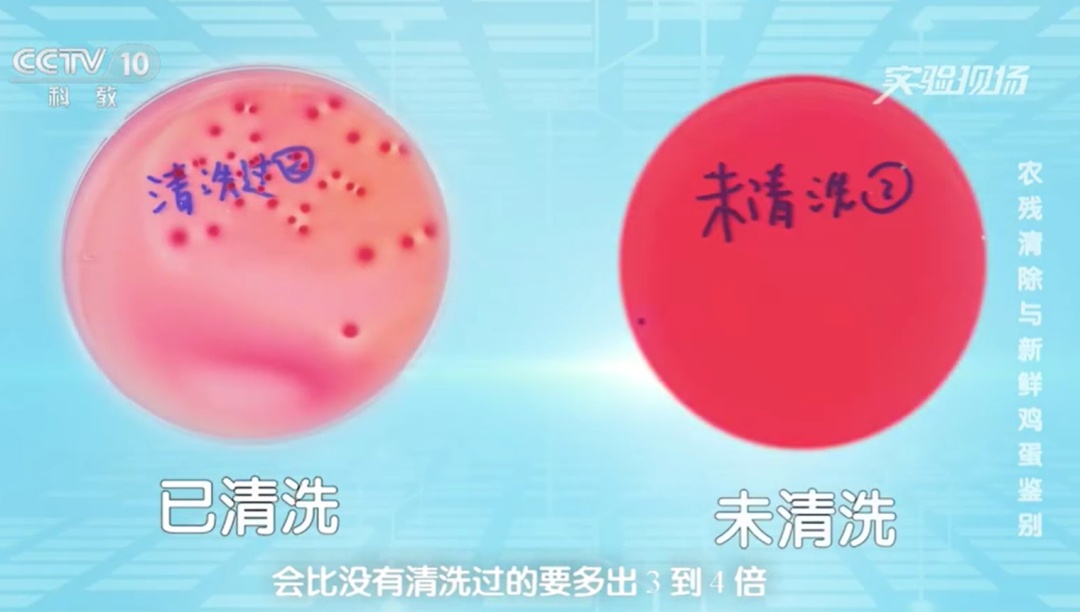
一家三口吃鸡蛋中毒！买回来的鸡蛋千万别这样做！

煎鸡蛋 蛋炒饭 番茄蛋
鸡蛋做法多种多样
营养丰富
是不少家庭最爱的食材
甚至最简单的水煮蛋
也能被研究出不同的煮法
不过鸡蛋处理不当
也会潜藏风险!!
日前
“一家三口吃清洗过的鸡蛋后中毒”
这一话题登上微博热搜

据早前报道,沈阳的一家三口,因为吃了炒鸡蛋,竟然出现中毒情况。经过调查,这一家人中毒的原因是因为食用了变质鸡蛋,而鸡蛋变质的诱因是因为保存前被清洗过!

清洗过的鸡蛋,从外表上看会更干净,但事实上并非如此。央视科教频道《实验现场》栏目带着一盒鸡蛋样品,来到中国农业科学院饲料研究所进行了相关实验。
鸡蛋变质的原因
专家分析,引起中毒的原因,可能是清洗过的鸡蛋病菌入侵,导致鸡蛋变质。经过实验发现,清洗过外壳的鸡蛋菌落比没有清洗过的多出3到4倍。
据介绍,鸡蛋在运输和储存过程中,表壳会附着大量细菌,比如沙门氏菌、金黄色葡萄球菌等对人体健康有害的有毒病菌。鸡蛋的表壳有一层交互膜,能有效减缓细菌入侵,清洗则会破坏这层膜,表壳携带的以及空气中的细菌就会从气孔进到鸡蛋内部,导致鸡蛋变质。人吃了这种鸡蛋之后容易刺激肠道,引发恶心、呕吐、腹痛、腹泻等不适现象。
鸡蛋如何正确保存
鸡蛋很容易被各种物质污染,怎样才能正确地保存鸡蛋,安全食用呢?
勿冷冻
冷冻会使蛋白质发生变化,导致蛋黄凝固,还有可能发生蛋壳破裂的情况。
忌冲洗
如果买回来的鸡蛋不干净的话,可以放入塑料袋或者盒中存放,在食用之前再把表面的污垢冲洗掉。
不混放
存放的鸡蛋外壳上有很多致病菌和污垢,不要买回来直接就放进冰箱,造成与其他食物的交叉感染。
别横放
放置鸡蛋的时候,注意将大的一头,也就是有气室的一头朝上,可以延长保存时间,还能防止煮蛋时由于蛋黄靠近蛋壳而散黄。
最后,要注意鸡蛋不能无限期地存放下去,一般来说,保存1至2周的鸡蛋食用是没有问题的,最长不要超过1个月。否则不仅营养成分会大量流失,还会变成“坏蛋”。
不少网友也
分享了自己的存放鸡蛋的经验



综合:央视网、大象新闻、网友留言


点击右上角![]() 微信好友
微信好友
 朋友圈
朋友圈

点击浏览器下方“ ”分享微信好友Safari浏览器请点击“
”分享微信好友Safari浏览器请点击“ ”按钮
”按钮

点击右上角 QQ
QQ

点击浏览器下方“ ”分享QQ好友Safari浏览器请点击“
”分享QQ好友Safari浏览器请点击“ ”按钮
”按钮
